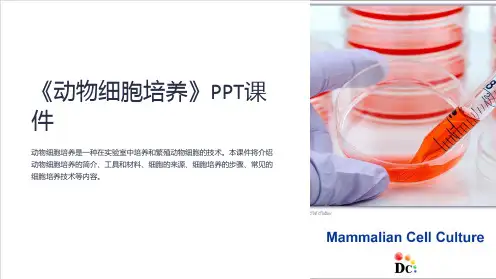

实战训练
3.动物和人体内具有分裂和分化能力的细胞称为干细胞。对右 图的相关叙述中,错误的是( ) A.a过程可表示干细胞的自我更新 B.b、c过程表示干细胞具有分化能力 C.a、b、c过程中细胞的遗传信息表达情况不同 D.a、b、c过程中遗传物质发生了定向改变
问题2:胚胎干细胞必须从胚胎中获取,这涉及伦理问题,因而限制了 它在医学上的应用。我们还有其他途径干细胞吗?
A.iPS细胞分化的实质是基因的选择性表达,细胞种类增多 B.iPS细胞分化成的多种细胞中所有核酸均相同,蛋白质却不完全相同 C.若将突变的相关基因替换,或许可以起到治疗该病的作用 D.经体外诱导产生造血干细胞,在小鼠骨髓中能够增殖分化出B细胞
实战训练
11.人体骨髓中的造血干细胞在体内环境下能分裂、分化形成红细 胞、白细胞和血小板。现代科学研究发现,在体外一定条件下培养 造血干细胞,它可以分裂、分化形成神经细胞。下列有关的叙述不 正确的是 ( )
容易发生突变 D.“iPS细胞”分化成人体多种组织细胞,是因为它具有不同于其他细
胞的特定基因
实战训练
9.有一个婴儿在出生后医院为他保留了脐带血,在他的生长发育过程中如果 出现了某种难治疗的疾病,就可以通过脐带血中的干细胞来为他治病,下列关 于这个实例说法正确的是( )
A.用干细胞培育出人体需要的器官用来移植治病,需要激发细胞的所有全能 性
实战训练
4.如图2-2-3是胚胎干细胞潜能示意图,相关叙述错误的是 ( ) A.由细胞形态判断,4种细胞中细胞②最可能连续分裂 B.胚胎干细胞能分化为各种细胞的实质是遗传物质相同 C.分化得到的各种细胞,功能不同的主要差异是特定蛋白不同 D.定向诱导胚胎干细胞分化形成组织或器官,进行自体移植可避免免疫排斥